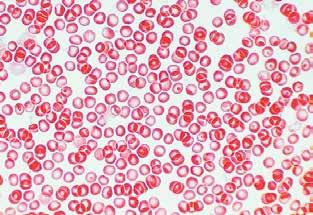

BiologyGeology and SECONDARY EDUCATION

4 12 MON T H S L I ECNEC DIGITAL PROJECT INCLUDED sample
The Scientific Method
1 Cells: the building blocks of life
• Gerti Cory. The cell chemist
1. The composition of living matter
2. Cells
3. Prokaryotic cells
4. Eukaryotic cells


5. The nutrition function in eukaryotic cells
6. Theinteraction function in eukaryotic cells
7. The reproduction function in eukaryotic cells


2 Genetic information
• Rosalind Franklin. X-rays and DNA
1. The nucleic acids
2. Gene expression. Protein synthesis
3. Thetransmission of genetic information
4. Mitosis and cytokinesis
5. Meiosis and sexual reproduction Understand, reflect and test your skills
3 Biological inheritance
• Francis Mojica. The value of basic research
1. From traits to genes
2. Mendel’s experiments
3. Mendel’s laws
4. Exceptions to Mendel’s laws
5. Mutations
6. Genetic engineering techniques
7. Applications of genetic engineering
Understand, reflect and test your skills
Contents Basic knowledge covered in the course
10
Science and
method
Research in the laboratory
Scientific research in the field 4. Searching for information RESEARCH PROJECT 26 CHALLENGES THAT LEAVE AN IMPRINT Bio Board Game 28
1.
the scientific
2.
3.
30
Understand, reflect and test
skills
your
48
66
88
Portfolio.
4 The origins
• Kamoya Kimeu. A tracker of ancestors
1. The origin of biodiversity
2. Early theories about the origin of biodiversity
3. Today’s evolutionary theories

4. Proof of evolution
5. Human evolution
6.
5 Dynamic earth
• Marie Tharp. Mapping the invisible
1. The composition and structure of the Earth’s interior
2. The Earth’s dynamics
3. The theory of plate tectonics
4. The consequences of lithospheric dynamics
5. The evolution of the Earth’s relief
6. Studyingthe relief: maps and profiles Understand, reflect and test your skills
6 The Universe
• Carl Sagan. Teaching people about space
1. The Universe
2. Galaxies and stars
3. The solar system
4. The Earth and the Moon
5. The Earth’s movements
7 The history of the Earth
• Mary Anning. Life amongst fossils
1. Recording the Earth’s history
2. Dating the Earth’s historical records
3. Geological time: a history of changes Understand, reflect and test your skills
8 Human beings and the environment
• Katsuko Saruhashi. Protector of the Pacific
1. The environment and its situation today
164
2. The sustainable management of biosphere resources
3. Sustainable water management
4. Sustainable energy management
5. Sustainable waste management
Annexes
CHALLENGES
AN IMPRINT All prepared for an eruption! 90
THAT LEAVE
life
of
and evolution 92
Hypotheses on the origin of life Understand, reflect and test your skills
114
140
6. Eclipses and tides
Understand, reflect and test your skills Portfolio. 160 CHALLENGES THAT LEAVE AN IMPRINT A time lapse of the Earth 162
7. Life in the Universe: astrobiology
182
Understand, reflect and test your skills Portfolio. 204 RESEARCH PROJECTS 206
CELLS: THE BUILDING BLOCKS OF LIFE 1
READING AND LISTENING

1 How do you think Gerty Cori felt when she:
a) was living in the aftermath of World War I?
b) was treated differently to her husband?
c) was the first woman awarded a Nobel prize in her category?

The cell chemist GERTY CORI
Have you ever thought about what your body is made of? It is a combination of organs that are made up of tissues. These tissues are a collection of cells, which are made up of all kinds of molecules. How do our bodies work on this tiny level? That was the question I kept asking myself.
My name is Gerty Cori. I was born in 1896 in Prague. As a teenager, I became interested in health so I worked hard to get a place at the University of Prague’s Faculty of Medicine. In a class there, I met Carl Ferdinand Cori. That distinguished-looking young man not only became my husband, but also my colleague, and I worked with him on research projects for the rest of my life.
In 1920, after marrying and getting my PhD, we moved to Vienna. I joined the paediatrics team at the
Children’s Carolinen Hospital, while Carl worked in a laboratory. Sadly, after World War I, Europe was in a state of misery, hunger and fear so, in 1922, we decided to emigrate and try our luck in the United States. Life wasn’t great for us there either. Carl and I were both researching cell metabolism. However, although he always defended my talent and experience, research centres were reluctant to give important positions to women. For years I earned much less than he did, even though we worked together and published joint articles. Luckily, my persistence won. In 1943, the School of Medicine of the University of Washington offered me a position as associate professor and, in 1947, as full professor. Finally!
That same year we were also awarded a Nobel prize for our most important discovery: the Cori cycle. This is the cyclical circulation of glucose and lactate between the muscle and the liver. Thanks to this discovery, I became the first women with a Nobel prize in Physiology or Medicine!

30
LANGUAGE BANK


SPEAKING

2 Gerty Cori was awarded the Nobel prize for her breakthrough discovery. Which scientific discoveries do you think were the most ground-breaking at the time of the breakthrough?
• In pairs, choose three major discoveries, then put them in order of importance.

• How have these discoveries affected you?
I think computers were the most ground-breaking at the time because they paved the way for storing and sharing information.
CHALLENGES THAT LEAVE AN IMPRINT LEARNING SEQUENCE

CHOOSING A GAME
1.1 Create a game. You can model it on one you are already familiar with (based on asking questions, drawing pictures or guessing words). In teams, study the rule book for the game you have chosen. Then, draw a diagram to evaluate the pros and cons of using that game. Write down any issues your team has identified. If your game seems really complicated, think about whether you need to choose a different game.
1.2 Use card or cardboard to make a real board for your game, or create a digital one with an online tool such as Trivinet, Mobbyt or Genially.
I disagree. I think the discovery of antibiotics was a more important breakthrough than computers because of their impact on human health.
WRITING
3 Read through all the Sustainable Development Goals and choose one that you believe could make a big difference to quality of life in the modern world.
• Think about the different discoveries or inventions that have helped improve the situation for your chosen SDG.
• Make a simple visual aid to explain what the discoveries and inventions are and how they have changed the situation for the better.
• Finally, explain what more can be done to improve the situation.
DESIGNING THE COUNTERS, CARDS AND OTHER MATERIALS


2.1 If you need to, list and design the materials for the game: counters, timers, dice, etc.
2.2 Create the game cards with information from this unit: the composition of matter; prokaryotic and eukaryotic cells, and their functions. You can make real cards, or use an online tool to create digital ones.
+ for guidelines, go to anayaeducacion.es
31
THE COMPOSITION OF LIVING MATTER
Living beings, like all the rest of the matter in the universe, are made up of atoms that combine together. However, the chemical and structural complexity of living matter is much greater.


This is because biomolecules are hugely diverse chemically; living beings are organised into different levels of complexity that reach beyond simple molecules.


1.1 Levels of organisation
From smallest to largest, the levels of organisation of living beings are: atoms, molecules, organelles and cell structures, cells, tissues, organs and systems. These then form organisms, populations, the ecosystem and the biosphere.
Each level is made up of the elements in the level below it, and forms part of the level above it. At each level, the matter gains new properties.
These properties, which were not present in the level below, are called emergent properties. For example, when all the tissues that form the heart join together, they acquire the property of being able to pump blood.


There are some living beings that do not have all the levels of organisation. Some organisms, such as protozoa, are unicellular and only reach cell level. Other organisms, such as algae, are multicellular but do not form tissues.


Understand, think, investigate…
1 Write the levels of organisation of the following examples of living matter:
circulatory system
DNA

bacteria calcium

mitochondria blood bird colony
2 In your own words, explain the concept of emerging properties.
3 Look at the illustration. Create a similar diagram to show the levels of organisation of a plant. Do the same for a mushroom-forming fungus and for a unicellular organism, such as a protozoan. How are they different to the diagram on this page?
32 1
Levels of organisation 1 Atomic level 2 Molecular level 4 Cell level 6 Organ and system level 7 Organism level 8 Population level 9 Community level 10 Ecosystem level 3 Organelle level 5 Tissue level
1.2 The composition of living matter
Living beings are made up of two types of substances: inorganic substances, and organic substances (biomolecules):
- Inorganic substances. These are found in both living and non-living matter. They are water and mineral salts.
- Organic substances, or biomolecules. Also called macromolecules, they are very complex. These molecules are exclusive to living beings. The main types are carbohydrates, lipids, proteins and nucleic acids.

Substance
Water
Mineral salts
Carbohydrates
Proteins
Nucleic acids


4 The What If. Explain what would happen in the cells a) if water didn’t exist, and b) if DNA didn’t exist. To learn how to apply this tool, look it up at anayaeducacion.es
Main functions
Structural function. Water is the main component of organisms and it gives the cells volume.
Metabolic function. All the cell’s chemical reactions take place in water.
Transport function. It is the medium that transports most substances within organisms. Thermoregulatory function. It helps maintain body temperature.
Structural function. For example, carbonates form the shells of many animals, and phosphates are deposited in bones.
Regulatory function. For example, some minerals, such as calcium, sodium and potassium, regulate the transmission of nerve impulses; while calcium plays a fundamental role in blood clotting.

Energy-producing function. For example, glucose, which is the cell’s main source of energy.

Energy-storage function. For example, starch, which is stored in plant cells; or glycogen, which is found in liver and muscle cells in animals.
Structural function. For example, cellulose, which forms part of the cell walls of plant cells; or ribose and deoxyribose, which form part of the structure of nucleic acid.
Other functions. Glycoproteins, for example, are carbohydrates joined to some proteins in cell membranes that help cells recognise each other.
Energy-storage function. For example, triglycerides, which are stored in cells.
Structural function. For example, cholesterol and phospholipids, which make up the base of all cell membranes.


Regulatory function. For example, sex hormones regulate processes such as sexual reproduction. Other functions. The pigments xanthophyll and carotene, for example, participate in photosynthesis.
Structural function. Many proteins form part of cell structures, such as the proteins in the cell membrane. Enzymatic function. Enzymes are responsible for accelerating the chemical reactions of metabolism. Examples include amylase, which breaks down starch; and lipase, which breaks down lipids.
Transport function. For example, the haemoglobin in blood, which transports oxygen.
Other functions. Examples include antibodies, which defend the organism against pathogens; actin and miosin, which are responsible for muscle contraction; and others, such as ovalbumin, which are storage proteins.
The nucleic acids are DNA (deoxyribonucleic acid) and RNA (ribonucleic acid). These molecules contain the genetic information of cells. They transfer this information to offspring, and use it to control cell function.

33 UNIT 1
Understand, think, investigate…
CELLS
Since the 19th century, we have known that all living things are made up of cells,
The cell is the smallest unit of a living organism that can carry out the vital functions: nutrition, interaction and reproduction.
structure of cells
Understand, think, investigate…
1 What is a cell? Write a definition.
2 Explain the basic functions of each of the structures found in all cells. What would happen if any of them were missing?
3 See the ‘Cell theory’ resources at anayaeducacion.es and answer the following questions:

a) Who was the first person to observe cells?
b) Who said: ‘All cells are produced from other cells’? Explain what it means.
c) Why do you think perfecting the microscope helped scientists present cell theory?
The cells of living things are not all the same, they come in a wide variety of sizes, shapes and structures.
2.1 Cell structure
There are a series of structures that are common to all cell types (cell membrane, cytoplasm, DNA and ribosomes); while others are specific to certain cells (chloroplasts, cilia, flagella, etc.).
Structures common to all cells
The structures common to all cells are:
- The cell (or plasma) membrane, which is the thin covering that surrounds the cell and separates the contents from the outside. It regulates the exchange of substances between the cell’s interior and the medium that surrounds it. It also detects stimuli from the external environment and allows communication between cells.
- The cytoplasm, which is the jelly-like substance that fills the cell, and is the medium the cell contents are found in. In all cells there are small particles called ribosomes, which synthesise proteins. Moreover, depending on the type of cell, there are different types of membranous organelles in the cytoplasm.
- The cells’ genetic material is DNA, a biomolecule that contains the information needed to regulate each cell’s function. This information is called genetic information
- There are two types of cell organisation, depending on where the cells’ DNA is located:
• Prokaryotic cells. These are small, simple cells that have no nucleus or membranous organelles. Their genetic material is scattered throughout the cytoplasm.
• Eukaryotic cells. These are larger, more complex cells. They have a nucleus, which contains genetic material, and a wide range of membranous organelles.

34 2
Nucleus
Centrioles
Mitochondria
Endoplasmic reticulum
The
Cell membrane
Golgi apparatus
Ribosomes
2.2 The size of cells
- The unit used to measure cells is the micrometre or micron ( μ m). A micrometre is a thousandth of a millimetre.


- The smallest cells are bacteria, which are generally between 1 to 2 μm in length.


- Animal cells come in many different sizes. For example, red blood cells measure 7 μm, liver cells 20 μm, spermatozoa 53 μm and ova around 150 μm.

- Plant cells can vary between 10 and 100 μm.


2.3 The shapes of cells
Cells share some basic characteristics, but not all of them are the same shape or have the same organelles. They also perform different activities.
Each type of cell has a structure and some specialised functions that allow it to carry out its activity as efficiently as possible.
For example, neurons are long cells with appendages that generate and transmit nerve impulses, spermatozoa are cells with mobile flagella that propel them through a liquid medium, intestinal epithelial cells have microvilli that increase the surface area to improve absorption, muscle cells are generally long so they can contract, red blood cells are biconcave so they can carry as much oxygen as possible, etc.

Different types of cells
Look at the cells in the pictures and answer the questions:
a) What shape are the cells in the pictures? Describe them.
b) What type of cells do you think they are?
c) Use the scales in the photographs to calculate the approximate size of the cells. Which is largest?
35 UNIT 1
Cell shape and size 30 μm 0,05 mm A B
PROKARYOTIC CELLS
Understand, think, investigate…
1 Compare the picture of this bacterium to the diagram on this page. Which structures can you see in it? Use the scale to calculate its real size.
Prokaryotic cells are exclusive to the living things that make up Kingdom Monera, such as bacteria. They are tiny unicellular organisms that exhibit the simplest form of cell organisation. They do not have a nucleus that separates the genetic material from the cytoplasm, or organelles surrounded by a membrane that perform specific functions.
3.1 What are prokaryotic cells like?
In addition to the structures that are common to all cells (cell membrane, with a double layer of lipids and proteins inside; genetic material or DNA; cytoplasm and ribosomes), prokaryotic cells have the following specific characteristics:
- They have a large DNA molecule or circular chromosome, which occupies a region called the nucleoid. Sometimes it contains small circular fragments of DNA called plasmids
- Their cytoplasm does not contain organelles, with the exception of ribosomes, which are smaller than those in eukaryotic cells.
- They have an outer rigid cover, the cell wall, which surrounds the cell membrane and gives the bacteria its shape. Their chemical composition is different to plant-cell walls. Some bacteria develop a capsule that surrounds the cell wall and gives them more protection.

- Some species have protrusions, such as flagella (which are long and are used for locomotion), and fimbriae (which are short and used to attach themselves to other cells and surfaces).
2 The cell wall is a characteristic structure of prokaryotic cells. You know its function, so what advantages do you think it provides?
- Some bacteria also have small filaments called pili on their surface that are used to exchange genetic material with other bacteria.

36 3
Genetic material
1 μ m
Cell membrane Ribosomes Cytoplasm Capsule Flagella Plasmid
Cell wall
3.2. The vital functions in bacteria

Nutrition
As bacteria do not have membranous (membranebound) organelles, all their nutritional processes take place in the cytoplasm. They can be autotrophic or heterotrophic.



- Most autotrophic bacteria are photosynthetic, so they use the energy from the Sun to synthesise organic compounds from inorganic matter in the environment. However, there are some bacteria that perform an autotrophic process called chemosynthesis. In this process, the bacteria synthesise organic compounds, using the energy released in chemical reactions.
- Heterotrophic bacteria feed on the organic matter of other living beings, and can be parasitic, saprophytic or symbiotic.
Interaction
Some bacteria use flagella to move. Spiral bacteria turn like a screw, others rotate on their axis, some slide over surfaces, and others remain immobile. Bacteria normally live in isolation, but occasionally form colonies.




Reproduction
Bacteria reproduce through binary fission. The cells duplicate their DNA and divide their cytoplasm into two halves. Each half will have a bacterial chromosome and a part of the cell’s content.
Understand, think, investigate…
3 At anayaeducacion.es Look at the resource ‘Heterotrophic nutrition in bacteria’. Explain the difference between parasitic, saprophytic and symbiotic bacteria, giving an example of each type.
4 How are photosynthesis and chemosynthesis similar? How are they different?
5 Bacterial division is a very quick process. In optimum conditions, bacteria can divide every half hour to create twice as many individuals. If you start with a single bacterium, how many bacteria will there be after thirty hours?
Some forms of flagellar movement in bacteria
Binary fission

1 The bacterium grows to full size and duplicates its genetic material (DNA).
2 The bacterium narrows in the middle and divides its content.
3 Two daughter cells are created.
37 UNIT 1
Forwards Rotating Forwards and rotating Rotating
EUKARYOTIC CELLS



Organisms with eukaryotic cells belong to Kingdoms Protista, Fungi, Plantae and Animalia, and can be unicellular or multicellular. Eukaryotic cells are larger than prokaryotic cells. They are characterised by having a nucleus surrounded by a membrane, which protects the genetic material (DNA) inside. The shape varies, as it depends on the function, the age and the organism.
4.1 What are eukaryotic cells like?
All eukaryotic cells:
- Have a nucleus, in other words, their DNA is surrounded by a membrane.
- Have a cytoskeleton, which is a network of filaments that give the cells their shape and enable them to move.
- Contain a wide variety of organelles and structures. Their shapes and functions are detailed in the tables on the following pages. Some of the organelles (mitochondria, Golgi apparatus, endoplasmic reticulum, etc.), are found in all eukaryotic cells. However, others are specific to certain types of cells, as you can see in the diagrams on this page.
4.2 Types of eukaryotic cells
- Animal eukaryotic cells, such as those that make up animals and some unicellular organisms, including protozoa.
- Plant eukaryotic cells, which are found in plants and algae.
Understand, think, investigate…
1 The mirror. Study the pictures of the cells. Copy and complete this chart in your notebook (learn more about this tool at anayaeducacion.es).

38 4
Cell membrane Cell wall Mitochondrion Golgi apparatus Ribosomes Chloroplast Endoplasmic reticulum Cytoskeleton Cytoplasm Nucleus Lysosomes and other vesicles Vesicle Vacuole Cell membrane Mitochondrion Golgi apparatus Endoplasmic reticulum Cytoskeleton Centrioles Cytoplasm Nucleus Lysosomes and other vesicles Ribosomes
? ? ? ? ? ? Different features Different features Similarities Animal eukaryotic cell Plant eukaryotic cell Eukaryotic animal cell Eukaryotic plant cell
4.3 The cell nucleus
Eukaryotic cells have a nucleus, in other words, their DNA is surrounded by a membrane.
The most important functions of the nucleus are that it contains the hereditary information, which determines the characteristics of the cells and the organisms they are part of, and that it controls cell activity.

The structure of the interphase nucleus
When the nucleus is not in the division phase (a period called interphase), the structure is more or less spherical, with a specific size for each type of cell. We can see the following elements:
- The nuclear membrane. This is actually made up of two membranes. It has a series of pores in it that enable the exchange of substances between the nucleus and the cytoplasm.

- The nucleoplasm. This is the thick, aqueous substance inside the nucleus, where the synthesis of nucleic acids takes place.
- The nucleolus. This is a spherical structure, formed by DNA, RNA and proteins. The components of the ribosomes are synthesised inside.
- Chromatin. This is the genetic material of the cell, the most important component of the nucleus. It is made up of DNA joined to proteins called histones. Under an electron microscope it looks like a mesh of interwoven fibres.
The structure of the nucleus during division
During cell division, metabolic activity decreases and the nucleus undergoes the following transformations:
- The nuclear membrane disappears, releasing the nucleoplasm.

- The nucleolus disintegrates.
- After replicating (making copies of themselves), the chromatin fibres condense and curl up, becoming shorter and wider until they are transformed into chromosomes, which are visible under an optical microscope. Each chromosome is made up of two chromatin fibres (the two copies resulting from the replication of the chromatin), called sister chromatids, which are joined together at the centromere. There are different types of chromosomes according to the location of the centromere.
Look at the pictures and do the following activities:
a) Create a table with the similarities and differences between chromosomes and chromatin.
b) Work out the function of histones and explain it in your own words.
39 UNIT 1
Interphase nucleus Nucleus in division: chromosomes Nucleolus Nuclear membrane Nucleoplasm Chromatin Sister chromatids Arm Chromatin fibre Centromere Histones DNA double helix
Structure Function
These are oval structures with a double membrane: the outside is smooth and the inside is folded.


Cellular respiration takes place in the mitochondria. Through this process the cell obtains energy from nutrients in the presence of oxygen.

Small structures attached to the endoplasmic reticulum (ER) and dispersed throughout the cytoplasm. They are made up of two subunits.
Ribosomes synthesise a cell’s proteins.
A collection of stacked, flattened sacs that vesicles are released from.
The Golgi apparatus modifies substances, packages them in vesicles and transports them to different parts of the cell, or outside it.

This is made up of a set of interconnected sacs and channels. The rough endoplasmic reticulum (RER) has ribosomes attached to it; the smooth endoplasmic reticulum (SER) does not have them.

The rough endoplasmic reticulum (RER) synthesises proteins via the ribosomes that are joined to it, and stores them or transports them to the Golgi apparatus. The smooth endoplasmic reticulum (SER) synthesises lipids.
Lysosomes are vesicles that originate in the Golgi apparatus and are full of hydrolytic enzymes. Other vesicles related to Golgi apparatus activity contain other types of substances.
Lysosomes perform cellular digestion, in other words, they decompose substances to obtain other simpler substances that are used in cell activity. Other vesicles related to Golgi apparatus activity have different functions, such as storing substances, transporting them, etc.
They direct the movement of the cytoskeleton and are involved in the formation of structures that produce cell movement, such as cilia and flagella. They also direct the separation of the chromosomes during the division of the cell.

40 4 EUKARYOTIC CELLS
These are two hollow cylinders made up of filaments.
Organelles common to all cells
Team work
Estructura
Orgánulos no comunes a todas las células
Organelles not common to all cells
Structure Function
These are protrusion of the membrane. The cilia are short and numerous, whilst flagella are long and fewer in number.


Son prolongaciones de la membrana. Los cilios son cortos y numerosos, mientras que los flagelos son largos y presentes en menor cantidad.
Cilia
Son características de las células vegetales. Se trata de grandes vesículas membranosas rellenas de agua y otras sustancias, como sales, azúcares y proteínas.
These are characteristic of plant cells. They are large membranous vesicles that are filled with water and other substances., such as mineral salts, sugars and proteins.
Permiten la locomoción de las células y el movimiento de las partículas del medio que rodean a la célula.
They enable cell locomotion and the movement of the particles in the environment that surrounds the cell.
Large vacuoles maintain the rigidity of plant cells as the liquid they contain creates pressure inside the cell.


La función de las grandes vacualas está relacionada con el mantenimiento de la rigidez de la célula vegetal ya que el líquido que contiene ejerce presión en el interior celular.
Son orgánulos ovalados y con doble membrana, las dos lisas.. En su interior tienen unos sacos aplanados llamados tilacoides y contienen un pigmento llamado clorofila, que les da el color verde característico a las células vegetales.
These are oval organelles with a double membrane. Both membranes are smooth. Inside there are flattened sacs called thylakoids that contain a pigment called chlorophyll, which provides the characteristic green colour of plants.


Es una envoltura externa a la membrana plasmática. Algunas células eucariotas presentan esta estructura, siendo su composición diferente, por ejemplo, la pared de las plantas contiene celulosa y la de los hongos, quitina.
This is an external covering outside the cell membrane. The composition of the structure in the cells that have it varies. For example, the cell wall of plants contains cellulose, while that of fungi contains chitin.
As you have seen on these pages, cells are very complicated. They have many parts that need to interact for them to carry out their functions. If you want to learn a bit more about these cell parts, work in groups to study the components and their functions in depth.
Each group should choose one of the organelles on this page, a part of the nucleus, or the cell membrane and create a fact sheet with the following information:


The process of photosynthesis takes place in the chloroplasts.
En los cloroplastos tiene lugar el proceso de la fotosíntesis.
La pared celular protege y proporciona rigidez a la célula.
The cell wall protects the cell and provides rigidity.


a) A description and diagram of the structure.
b) A microscopic photo showing the detail of the structure.
c) A detailed description of the functions and their importance for the survival of the organism.
d) Some structures are more important or more abundant in some types of cells, such as mitochondria in the muscle tissue. Is this the case with the structure you chose?
e) Display your research project in class.
41 UNIT 1
THE NUTRITION FUNCTION IN EUKARYOTIC CELLS

Nutrition is all the processes that provide cells with the matter and energy they need to grow, replace their structures, divide and interact.
5.1 The exchange of matter
The cell membrane is a selective barrier that allows or helps certain substances pass through, while stopping others.
These substances pass through in different ways depending on their size.
Transport through the membrane
Using the diagram for reference, explain how you think the following substances pass through the cell membrane:
a) Na+
b) Carbon dioxide.
c) Mineral salts.
d) A bacterium.
- Via diffusion. This happens when the substances are small, such as oxygen, carbon dioxide and mineral salts.
- Via proteins. When the substances are larger, or have a charge (ions), the proteins form channels or pumps (structures that ‘pump’ the substances) that the molecules pass through.
- Forming vesicles. When the substances are very large, the membrane dips inwards and wraps around the particle, creating a vesicle that passes into the cell cytoplasm. This process is called endocytosis. The opposite process is exocytosis.
42 5
ENERGY Through diffusion (down the concentration gradient). Through channels (up the concentration gradient). Through pumps (up, or against, the gradient; energy required). Vesicle Lysosome Digestion Vesicle with nutrients Remains of digestion (waste)
or charged particles
Medium-sized
Smallparticles Largeparticles
5.2 Energy exchange
The substances transported into the cell undergo a series of chemical reactions. They are either transformed into matter or cell structures, or used as an energy source for the cell to perform its vital functions. Many chemical reactions take place in a cell, and they constitute its metabolism, which can be one of two types:

- Catabolism. This is the set of cellular chemical reactions through which complex molecules break into fragments and transform into other, simpler, ones. The process releases energy, which the cell uses during anabolism or to produce cell movement, for example. Cell respiration is an example of a catabolic process that occurs in the mitochondria of eukaryotic cells.
- Anabolism. Anabolism is a set of cellular chemical reactions that converts simple molecules into more complex ones, such as proteins, lipids, etc. The cell then uses these to form its components. The formation of these biomolecules requires a supply of energy, which comes from the catabolic reactions. Photosynthesis is an example of an anabolic process that occurs in autotrophic cells.
Understand, think, investigate…
1 Define cell metabolism and explain the difference between anabolism and catabolism.
2 Find out what fermentation is. In your notebook, explain what it is and whether it is a catabolic or anabolic process.

3 Look at the following diagram. Order the stages of the process and match each letter to the corresponding stage:
a) Part of the energy generated is used in anabolic reactions to construct proteins, nucleic acids, lipids, etc.
b) The food is incorporated into the cell and digested with the help of the lysosomes.
c) Another part of the energy is used to perform other cell functions, for example, reproduction, movement, etc.
d) The CO2 produced during respiration leaves the cell through diffusion.
e) In the presence of oxygen, the mitochondria use the organic matter, transforming it into CO2 and water.
f) Energy is released in this process, which is called respiration.
g) The complex molecules are transformed into simpler ones.

43 UNIT 1
ANABOLISM Simple molecules Complex molecules CATABOLISM Energy Energy CO2 O2 Energy 3 7 6 4 5 2 1 Metabolism
THE INTERACTION FUNCTION IN EUKARYOTIC CELLS
Static response
Transmitter
A cell’s interaction function is its ability to respond to a stimulus in the environment.
6.1 Stimuli and responses
Secreted substances
The changes that trigger a cellular response are called stimuli. Stimuli can be: chemical, such as changes in the composition of the environment or changes in the pH; and physical, such as changes in temperature or pressure.
Receptor
When the transmitter is joined to the receptor, the cell responds by secreting substances.
Dynamic response
Ciliary and flagellar movement

By beating the cilia, the protozoan can swim around in the environment.
Some cells have a flagellum that snaps like a whip to enable them to move quickly.



Cellular response is the reaction of a cell to stimuli. They can be one of two types: static or dynamic responses.
- Static response. There is no movement produced in this type of response but the cell responds in a different way; for example, secreting a substance.
- Dynamic response. In this type of response, the cell responds by moving. Together these movements are called taxes. They are considered positive if the cell moves towards the stimulus, and negative if it moves away from it.
6.2 Cell movements
Cell movement is closely linked to the cytoskeleton, which has filaments that form contractile structures in the cytoplasm and protrusions that enable it to move. The main types of movement are:
- Flagellar movement. This movement is produced by cilia and flagella, which are prolongations of the cytoplasm containing fibres that are similar to the cytoskeleton.
Contractile movement
When faced with external stimuli, this protozoan (Vorticella) contracts the stalk that attaches it to a substrate.
Amoeboid movement
The amoeba sends out projections of its cytoplasm, or pseudopods to capture the bacteria.


Pseudopods
- Contractile movement. This is produced by the fibres of the cytoskeleton contracting and stretching, changing the length of the cell.
- Amoeboid movement. This movement is produced by prolongations of the cytoplasm, known as pseudopods, which are directed by the cytoskeleton.
Understand, think, investigate…
1 Create a diagram to show amoeboid movement.
2 Give some examples of cells that exhibit amoeboid movement, flagellar movement and contractile movement. Do not use the examples shown in the illustration.
44 6
Flagellum Cilia Stalk
THE REPRODUCTION FUNCTION IN EUKARYOTIC CELLS

Cellular reproduction (or cell division) is the ability of a cell to divide into two identical daughter cells.

7.1 Cell division
Cell division takes place in both unicellular and multicellular organisms.


- In unicellular organisms, such as protozoa, cell division allows the organism to reproduce.
- In multicellular organisms, cell division allows the organism to increase in size and regenerate tissue; in other words, to replace cells that die off.
7.2 Types of cell division
Eukaryotic cells have different cell-division mechanisms:
- Binary fission. The cell duplicates its DNA and generates two daughter cells that are genetically identical and the same size. Protozoa are good examples of eukaryotic cells that divide through binary fission.
- Budding. The cell duplicates its DNA and generates a bud, which develops and separates from the mother cell. Two daughter cells are formed, which are genetically identical but have different sizes. This is how unicellular fungi, such as yeasts, reproduce.
- Sporulation or multiple fission. The cell generates many copies of its DNA, which surround themselves with a portion of cytoplasm. The parent-cell membrane breaks up, releasing spores. This is how fungi, many plants and some protozoa reproduce.
Cell division
The diagrams show the three types of cell division in eukaryotes. Look at them carefully and answer:
a) Which type of cell division does each diagram represent?
b) Give an example of living beings that exhibit this type of cell division.
c) In your notebook, write a description of how each type of division occurs.
45 UNIT 1 7
A B C
REVIEW & PRACTISE
UNDERSTAND
Organising your ideas

1 Venn diagram. In your notebook, complete the following Venn diagram on the common and specific characteristics of different types of cells. To learn how to do this, check out the resource at anayaeducacion.es Prokaryotic
3 Look at the pictures and answer the questions for each of them.
Summarising
2 Create your own summary of the unit following these guidelines:
• Put the levels of the organisation of matter in order, and name the inorganic substances and the organic biomolecules, indicating their main functions.
• Explain what prokaryotic cells are like and how they are organised, and describe the different types by their nutrition.
• Explain how prokaryotic cells reproduce and interact.
• Compare an animal cell and a plant cell. Describe the function of the organelles that are specific to each type, and the function of the organelles they have in common.

• Establish the difference between the nucleus of a eukaryotic cell in interphase and in division.
• Explain how matter and energy is exchanged between a cell and the environment.
• Define stimuli and explain how cells respond to them.
• Explain how and why a eukaryotic cell reproduces.

a) What kind of organelle is it?
b) What is its function?

c) In which cells is it found?
4 Look at the cell in the picture and name the organelles you can see.




5 Explain this cell’s movement in each picture. Which structures create these movements?

46
– Plasmids – Capsules – Pili –?
– Centrioles –?
– Chloroplasts – Large –? Cell wall DNA ?
cell
Animal eukaryotic cell
Plant eukaryotic cell
B E A C D
1 2
? ?
Remember to choose resources from this unit for your portfolio.
Applying your knowledge
6 Draw a prokaryotic cell and label it to show the functions of the different structures.
7 How does a heterotrophic prokaryotic cell get its nutrition? And an autotrophic cell that lives in the dark?
8 Explain why it is important to know a person’s karyotype and when it might be needed.
9 White blood cells can take bacteria into them as a defence mechanism. Explain the process they use to pass them through their membrane and which organelle is involved in their digestion.
10 Match each sentence to a type of cell movement:
11 Typical of white blood cells.
12 Produced through the vibration of cilia and flagella.
13 Performed by muscle cells.
14 Explain why cell division is different for a unicellular organism and for a multicellular organism.
15 Explain the difference between:
a) Binary fission and budding.
b) Budding and sporulation.
c) Anabolism and catabolism.
16 Explain why photosynthesis is an anabolic process.
Moving forward
17 Read the following text and answer the questions.
Bacteria are very diverse organisms. They have colonised every environment on the planet after millions of years of evolution. There are two large groups of bacteria: archaea and eubacteria.
Archaea are extremophiles, which are able to survive in high temperatures, very salty environments, and even without oxygen, thanks to the particular chemical composition of their cell wall and membrane that makes them very resistant.
Eubacteria are subdivided into several groups, such as Gram-positive and Gram-negative bacteria, which differ in the composition of their cell walls; and mycoplasmas, which do not have a cell wall.
a) What type of cell organisation do bacteria exhibit?
b) Create an outline to show the different groups of bacteria mentioned in the text.
c) Do some research into Gram staining. What does the technique consist of? What is it used for?

LEARNING SITUATION
REFLECT AND ASSESS
In this unit you have studied the main types of cells and their characteristics. You have also analysed their main components and looked in depth at the vital functions of eukaryotic cells. Reflect on what you have learned and complete this self-assessment questionnaire and the rubric at anayaeducacion.es Assessment
I can answer questions about the types and characteristics of cells and give detailed explanations.
I can interpret information about cells and create my own information in digital and physical formats.
I can analyse and interpret information about the vital functions of cells.
TEST YOUR SKILLS
At anayaeducacion.es complete the self-assessment worksheet to test your skills.


UNIT 1
CHALLENGES THAT LEAVE AN IMPRINT 47
Yes With help Not yet
descriptor
47
2 GENETIC INFORMATION
ROSALIND FRANKLIN X-rays and DNA

There are countless miniscule things that we can’t see with the naked eye, that’s why my eyes alone were never enough. I learnt to use X-rays to explore this undiscovered world.
My name is Rosalind Franklin. I was good at science as a child, so I decided to study Physics and Chemistry at the University of Cambridge. My father didn’t like the idea to begin with, but luckily an aunt helped me financially. My father soon understood that I was going to be a scientist, whether he liked it or not.
At university I met Nobel prize winner Professor William Lawrence Bragg. His new technique used X-rays to observe the distribution of atoms in a crystal. Over the years I learnt, practised and improved the method, becoming an international expert.
READING AND LISTENING

1 How do we know that Franklin wasn’t pleased that Watson and Crick did not recognise her contribution?

2 Write a paragraph summarising the key points mentioned in the text.
In 1951, I was given a position at King’s College London and began work, applying my X-ray diffraction techniques to DNA. One of my photographs, number 51, was particularly revealing. My colleague Maurice Wilkins, who I didn’t like very much, showed it to colleagues – James Watson and Francis Crick – without my knowledge. They had been studying the structure of DNA for years. My photograph provided a key piece of evidence. They completed their chemical model and published their findings on the double helix structure in 1953.
My part in the discovery was not recognised at that time, so I decided to change laboratory and focus on studying viruses. I did this until I died from ovarian cancer in 1958. Four years later, Watson, Crick and Wilkins shared a Nobel prize for their discoveries related to DNA. Who knows… if I had been alive then, maybe my name would have been on that list.
48
LANGUAGE BANK


SPEAKING

3 Do you think that if Franklin had lived for another four years, she would have received recognition for her part in her peers’ discovery? Would she have shared the Nobel Prize?

Explain your opinions to a classmate.
I think if Franklin had lived for four more years, she would have received recognition because…

I don’t think she would have got a Nobel prize as she ….
4 Tell your classmates what you were passionate about when you were young. How old were you at the time?

WRITING
A newspaper article

5 You have been asked to write a short article about the work of microbiologists for your school newspaper. Do some research and include the information below.
• What do microbiologists do?


• What qualifications do they have?
• Where do they work?
• What is a typical day like for a microbiologist?

HOW THE GAME WORKS
3.1 In order to create a good game, you need to know the mechanics of how it works. The mechanics are the systems used in the game, for example, throwing dice, asking questions, or moving around a board. Do some research into how different games work and make a list of the systems you are using in your game. Explain how they relate to each other in the game.
3.2 Make the game cards with information from this unit: nucleic acids, replication, transcription, translation, mitosis and meiosis. You can use digital or physical card formats.
THE RULES
4.1 Decide on the rules of your game based on the game you are using as a model. Design an instruction booklet and write your rules in it
4.2 Play the game in your group to test it. Make sure you follow your instructions manual. Decide whether you need to make any changes to the rules, the materials or the mechanics of the game.
THE NUCLEIC ACIDS
In the second half of the 20th century, the chemical structure of chromosomes was discovered. This allowed us to understand its role as a carrier of genetic information. Genes, which are located in the chromosomes, are actually fragments of DNA, a molecule that carries the necessary information for a trait to be exhibited.
DNA is the molecule that carries genetic information and controls the emergence of traits through the synthesis of proteins. It can also transfer this information to daughter cells through duplication or replication.
1.1 DNA molecules
The DNA molecule is formed by two complementary chains of nucleotides twisted into a double helix*

DNA is made up of two smaller sub-units called nucleotides. In turn, each nucleotide is formed by the union of a sugar (deoxyribose), a phosphate group and a nitrogenous base. There are four different types of nitrogenous base: adenine (A), thymine (T), cytosine (C) and guanine (G). The nucleotides are joined together by a bond between the phosphate group of one nucleotide and the sugar of the next.
The double helix model
In 1953, Francis Crick and James Watson proposed a model for the structure of DNA based on the work of Rosalind Franklin and Maurice Wilkins. According to this model:
- The DNA molecule is a double helix formed by two twisted chains of nuceotides.
- The nitrogenous bases form the inside of the helix and the sugars and phosphate group form the skeleton.

- Both chains remain joined together by weak bonds that are established between the bases of the nucleotides that are opposite each other in the structure.
- They do not bond randomly; thymine bonds to adenine, and cytosine bonds to guanine. This means the chains are complementary; in other words, the succession of bases in a chain of nucleotides determines the succession of bases of the other chain. This complementary nature of the nitrogenous bases is the basis for DNA replication.
50
Structure of a nucleotide Nitrogenous base Phosphate group Pentose sugar: ribose or deoxyribose A A A A G G G T T T T C C C Phosphate group Nitrogenous base Deoxyribose DNA 1
1.2 RNA molecules
RNA is a nucleic acid and its main characteristics are:
- It is single-stranded, which means it does not form double chains except in some types of virus, such as reoviruses.
- It is also made up of nucleotides. Each nucleotide is made up of the union of a sugar (ribose), a phosphate group and a nitrogenous base that can be adenine (A), uracil (U), guanine (G) or cytosine (C).
- RNA strands are smaller because they have fewer nucleotides.

- Their three-dimensional structures can be very complex as they often fold up and create bonds with different areas of the same molecule.
- There are different types of RNA with different functions:
• Messenger RNA (mRNA): this is RNA that is synthesised from DNA in the nucleus. It contains the information to produce proteins in the cytoplasm.
• Ribosomal RNA (rRNA): this is made up of molecules of different sizes that form the structure of ribosomes.
• Transfer RNA (tRNA): this helps synthesise proteins by transporting the amino acids to the ribosomes.
Understand, think, investigate...
1 Define DNA and name the people who participated in the development of the double helix model.
2 Explain what a nucleotide is and how they join together to form DNA.
3 Explain the functions of the different types of RNA.
4 The mirror. Complete the table to compare DNA and RNA. Learn how to use this technique at anayaeducacion.es
Ripley’s DNA
The fact that biological inheritance is found in the DNA is considered general knowledge today. Many films, series and even press articles often use genetic terms, but do they always use them correctly?
In the 1997 film Alien: Resurrection, a clone of Ripley is created 200 years after her death. Using her DNA, they clone a complete human being who retains the memories of the original Ripley.
a) Do you think memory is the type of information that is transmitted in DNA? Explain your answer.
b) Look up two examples of DNA-related science blunders in series, films, novels, etc. and explain why they are errors.

51
A U U G C A Phosphate group Ribose sugar Nitrogenous base RNA
? ? ? ? ? ? ? ? ? Differentiating traits Differentiating traits Similarities DNA RNA UNIT 2
Parts THE NUCLEIC ACIDS
of a chromosome
1.3 Chromosomes
Chromosomes are structures formed by the condensation of the DNA and proteins – called histones – that appear when the cell is about to divide.
In eukaryotic organisms, the genome is made up of several different chains of DNA. During cell division, each of these DNA molecules is packaged and then coils up to create a chromosome.
In general, the following characteristics are true for the chromosomes of all eukaryotes:
- All cells in individuals of the same species have the same number of chromosomes. They are also the same shape and size. Mosquitoes of the species Aedes aegypti have 6 chromosomes; the fly Drosophila melanogaster, has 8; human beings have 46; dogs have 78; one species of fern has more than 500.
- Most cells have two sets of chromosomes, meaning the chromosomes appear in pairs. The chromosomes in each pair are called homologous chromosomes.
Chromatids
The number of pairs of chromosomes a species has is called the haploid number (n), and the total number of chromosomes, with both sets in pairs, is the diploid number (2n). Organisms that meet this condition are called diploids. This is the case, for example, in all the living beings in the animal kingdom. There are other living beings that are haploids, and others that are polyploids and have 3n, 4n or more chromosomes.
In many species, the cells of a specific sex have one pair of chromosomes which are not homologous. These are the sex chromosomes. The rest of the chromosomes in the cell are called autosomes. In these living beings, the sex of the organism is determined by the sex chromosomes. For example, dog cells (78 chromosomes) contain two sets n = 39. Of these, 38 pairs are autosomes and 1 pair consists of the sex chromosomes, which are X and Y for males, and double X for females.
Understand, think, investigate...
5 What is a homologous chromosome?

6 Define haploid number and diploid number.
7 Explain what autosomes and sex chromosomes are. Why do you think sex chromosomes are also known as heterochromosomes?
52 X
Centromere
8 Choose an animal species, find out how many chromosomes it has and draw a diagram to show what a haploid cell and diploid cell would look like for that species. Short arm Long arm
Types of chromosomes
Chromosomes can be classified by the position of the centromere on the arms.

- Metacentric chromosomes. The centromere is located in the middle of the chromosome. Its arms are roughly equal in length.



- Submetacentric chromosomes. The centromere is a bit nearer one end. The arms are slightly unequal in length.
- Acrocentric chromosomes. The centromere is very near one of the ends of the chromosome, which makes the arms very unequal.
- Telocentric chromosomes. The centromere is at the end of the chromosome, which means only one arm is visible.

The karyotype
A karyotype is a picture of the collection of chromosomes in a cell. It tells us the number, type and structure of the chromosomes that are characteristic of a species.

In a karyotype, the autosomes appear first, ordered into homologous pairs, from largest to smallest, and the sex chromosomes are located at the end.
Understand, think, investigate...
9 Look at the karyotype in the picture and answer the questions.
a) How many chromosomes can you see in this karyotype? Number them and say which are autosomes and which are sex chromosomes.
b) Would this karyotype be considered within the range of normality? Explain how it is different and find out what syndrome it corresponds to.
Types of chromosomes
The karyotype of a human cell. The colour represents the origin of each set of chromosomes (one from each parent). The autosomes are pairs 1 to 22, and the sex chromosomes are pair 23. In this case, they consist of two homologous sex chromosomes (XX).
53
1 6 13 19 20 21 22 XX 14 15 16 17 18 7 8 9 10 11 12 2 3 4 5
Centromere Telocentric Acrocentric
Metacentric Submetacentric
Diagram of a human karyotype
UNIT 2
GENE EXPRESSION. PROTEIN SYNTHESIS
DNA is the carrier of genetic information. A gene or fragment of DNA carries information that is generally expressed through the synthesis of a protein.
2.1 Transcription
Proteins are synthesised in the ribosomes, which are found in the cell cytoplasm (floating free or adhered to the endoplasmic reticulum). As the DNA remains in the cell nucleus, there has to be a mechanism that allows the information carried by the genetic material to be ‘transferred’ to the cytoplasm. This mechanism is transcription.
The genetic code
Look at the genetic code and answer these questions:
a) Which genetic code sequences would give the following sequence of amino acids: methionine-serinearginine-glycine-stop? Write two different sequences.
b) Different sequences of nucleotides can code the same amino acid. How is this useful?
Transcription takes place in the cell nucleus. The information contained in the DNA (according to the base sequences) is transferred to a molecule of messenger RNA (mRNA).
2.2 The genetic code
The correspondence between the mRNA codons and the amino acids that form the proteins is called the genetic code.

The genetic code determines how an mRNA sequence is translated into a sequence of amino acids for a protein. In this code, each trio of consecutive nucleotides, called a codon, corresponds to a specific amino acid.
The genetic code is degenerate, in other words, several different codons can code t he same amino acid, such as proline, which can be CCU, CCC, CCA and CCG. This helps reduce errors when the n nucleotides are placed during transcription.
54
A A A A A A C C C C C Second nucleotide First nucleotide Third nucleotide C G G G G G G U U U U U U Phenylalanine Histidine Leucine Glutamine Serine Tyrosine Cysteine Tryptophan Arginine Leucine Isoleucine Asparagine Serine Treonine Methionine Lysine Arginine Glycine Aspartic acid Alanine Valine Glutamic acid Proline Stop Stop
2
2.3 Translation
Translation consists of synthesising a protein molecule following the code contained in the mRNA molecule transcribed from a DNA sequence.
Translation * takes place in the cytoplasm and is performed by ribosomes. As well as the ribosomes, the process also involves the mRNA molecule, which has formed in the transcription process, and another type of RNA molecule, called transfer RNA (tRNA), which is in charge of transporting the amino acids to the ribosome.
There is a tRNA for each of the amino acids. This molecule contains a set of three nucleotides called an anticodon. The bases of the tRNA anticodon are complementary to the mRNA codon.
Translation
Look carefully at the illustration and answer the questions:
• In which part of the cell does transcription take place?
• Where do mRNA and ribosomes join together?
The mRNA resulting from the transcription of the DNA passes into the cytoplasm.
Once in the cytoplasm, the mRNA bonds to the ribosomes.
At the same time, the free amino acids bond to another special type of RNA, called transfer RNA (tRNA).
The protein grows as it reads the information in the mRNA and gradually the tRNA bonds to the corresponding amino acids.


Each amino acid, bonded to its tRNA, recognises a specific sequence of three mRNA bases (codon) and attaches to it, thereby creating a protein chain
tRNA loaded with amino acids transports them to the ribosomes.
Once all the mRNA chain has been read, the protein separates from the ribosome and floats freely in the cytoplasm.





55
Protein
Amino acids tRNA tRNA Ribosome Nucleus mRNA mRNA mRNA UNIT 2
THE TRANSMISSION OF GENETIC INFORMATION
3.1 The cell cycle
We can divide the life of a cell into different phases. This is called the cell cycle. In eukaryotic cells, the cell cycle is very complex. It is divided into two periods, the interphase and the mitotic phase.
Interphase
This is a long stage during which the cell grows, duplicates its DNA and prepares itself for division. It is divided into the G1 phase, the S phase and the G2 phase.
Mitotic or cell division phase

This is a brief phase during which the cell divides first its nucleus and then its cytoplasm.
- Mitosis or M phase. The cell divides its nucleus. In other words, the genetic material is shared between the two cells that are forming. Mitosis consists of four phases, called the prophase, metaphase, anaphase and telophase.

- Cytokinesis. The cell divides its cytoplasm and organelles between the two daughter cells that contain sets of chromosomes that are identical to the mother’s set.
S Phase:
The cell creates an exact copy of its genetic material (DNA duplication or replication).
G2 Phase:
G1 Phase:
The cell grows, and the organelles and cytoplasmic structures are duplicated.
PROPHASE METAPHASE ANAPHASE CYTOKINESISTELOPHASE
The cell undergoes a new stage of growth and reaches the right size for cell division. The centriole is duplicated during this phase.

56
INTERPHASE The cell cycle M phase or Mitosis 3
3.2 Replication
DNA replication is the process of synthesising two identical copies of the DNA molecule.








The replication is semi-conservative. This means that the double helix unfurls* and each chain acts as a ‘model’ for the creation of another complementary chain. DNA replication is performed by a specific enzyme, DNA polymerase, which bonds the nucleotides following the sequence on the model chain.
When this process has finished, two identical double helices will have formed, one of which goes to each daughter cell.
Replication
Focus on English
Twist – to form, or to make something else form, a twisted, curled or spiral shape.
Unfurl – when something unfurls it opens up.
Understand, think, investigate...
1 What is the difference between cells in the G1 phase and cells in G2 phase?
2 See the resource ‘Replication step by step’ at anayaeducacion.es. Why do you think it’s important that copies of both DNA strands are formed at the same time during replication?

1 The double helix unwinds and the molecule opens like a zip, separating both chains
2 Each DNA chain is duplicated independently, acting as a new model for the creation of a new complementary chain through the bonding of nucleotides (adenine with thymine, and guanine with cytosine).
3 The new molecules twists* into spirals to form the double helix structure. The final result is two new double helices, which are exact copies of the original molecule. Each one is formed by an old chain and a new chain.
57
UNIT 2
A A A A A A A A A A A A C C C C C C C C C C T T T T T T T T T T T T G G G G G G G G G G A A A A A A A A A A A A A A A A A A A A A A C C C C C C C C C C C C C C C C C C C C T T T T T T T T T T T T T T T T T T T T T T T T G G G G G G G G G G G G G G G G G G G G A A A A A A A A A A A C C C C C C C C C C T T T T T T T T T T T T G G G G G G G G G G 1 2 3 A A A A A A A A A A A A A A A C C C C C C C C C C C C C T T T T T T T T T T T T T T T G G G G G G G G G G G G A C T G G C
MITOSIS AND CYTOKINESIS
4.1 Mitosis
Mitosis is the process through which the division of the cell nucleus takes place.









The biological significance of mitosis
In multicellular organisms, the purpose of cell division by mitosis is to enable the individual to grow through successive divisions, as well as to regenerate deteriorated cells. In unicellular organisms, mitosis is an asexual reproduction mechanism for increasing the number of organisms of a species.
4.2 Cytokinesis
Cytokinesis is the process in which the cell divides its cytoplasm and organelles between the two daughter cells.


Cytokinesis varies from one type of cell to another, due to the different structures of their outer membranes. Animal eukaryotic cells are only surrounded by the cell membrane, meaning they can easily become deformed. On the other hand, in plant eukaryotic cells, the membrane is surrounded by a thick, rigid cell wall, which prevents them from being deformed.
The cell cycle and cancer

You know about the cell cycle, how mitosis occurs and the biological significance of the process, but did you know that many types of cancer are produced by alterations in the control of the mitotic process or the cell cycle?
Mutations, which we will study later, are changes that take place in the DNA sequence of organisms. Some very damaging mutations cause the cell to die in a process called apoptosis. However, sometimes the cell doesn’t die and can cause cancer.
Look at the diagram on the right and answer the questions:
a) Describe each part of the diagram in your own words.
b) Do some research and write an explanation of apoptosis.
c) Find out what metastasis is. Add a drawing to the diagram and write an explanation of the process.
58
Normal division Division of a cancer cell Carcinogenic factor Repair Tumour cells Cellular apoptosis 4
Mitosis and cytokinesis



• Each pair of centrioles migrates to one of the poles of the spindle apparatus, which is a bundle of cytoskeletal fibres that forms between them.
• The nuclear membrane disintegrates.
• The DNA condenses into chromosomes, formed by two sister chromatids.

• The centrioles remain at the opposite poles of the cell.
• The components of the nuclear membrane are dispersed throughout the cytoplasm.
• The chromosomes align along the midline of the cell and join to the fibres of the spindle apparatus.


• The centrioles begin to shorten the fibres of the spindle apparatus, pulling the chromosomes in opposite directions.
• The components of the nuclear membrane are still dispersed throughout the cytoplasm.
• The two sister chromatids of each chromosome separate, migrating to the poles of the cell.
• The centrioles shorten the fibres of the spindle apparatus, until it disintegrates.
• A new nuclear membrane forms around each set of chromosomes.
• The DNA in the chromatids decondenses until it forms chromatin.
Cytokinesis of an animal cell
Contractile ring
Cytokinesis
• The cytoplasm is divided through the cleavage of the membrane.
• A contractile ring forms midway around the cell, which gets narrower.
• Finally, the membrane breaks, this called a cleavage furrow, dividing the cell into two daughter cells.
Cytokinesis of a plant cell Phragmoplast
• The thick, rigid cell wall prevents cell cleavage.
• The division of the cytoplasm takes place through the formation of a plate at the centre of the cell known as a phragmoplast.
• The plate progresses from the centre of the cell to the outside, forming a cell wall between the daughter cells.


59 UNIT 3
Anaphase Metaphase Telophase
Prophase
MEIOSIS AND SEXUAL REPRODUCTION
5.1 Sexual reproduction

Sexual reproduction requires two parents to produce a new individual, and the offspring is a combination of the characteristics of both parents.
Organisms that reproduce sexually have two types of cells:
- Those that form part of the body are called somatic cells, and are diploid cells (2n).
- The cells specialising in reproduction, known as germ cells. These are diploid cells (2n) that, through a special division process called meiosis, become sex cells or gametes, which are haploid (n).
In this way, when fertilisation occurs, the male gamete (n) joins to the female gamete (n), to create the zygote or egg cell (2n), which has the same number of chromosomes as its parents.
5.2 Meiosis
Meiosis is the special division process though which haploid cells are formed. Gametes are formed through this process.
The biological significance of meiosis
Understand, think, investigate...
1 What does it mean when we say that an organism is a diploid, but its gametes are haploid?
2 How many chromosomes do human somatic cells and gametes have? Which of these cells are haploid and which are diploid?
3 Choose an animal that reproduces sexually and find out how many chromosomes its somatic cells have. Then, write down how many chromosomes its gametes will have.
4 Explain the biological importance of crossover during meiosis.
- Meiosis is an essential process that halves the number of chromosomes during the formation of sex cells. In this way, haploid cells (n), with one set of chromosomes, are obtained from diploid cells (2n), with two complete sets of chromosomes.
- During meiosis, as you will see in more detail on the following pages, there is a crossover, or exchange of sister chromatid fragments, between homologous chromosomes. This exchange of information creates cells that are genetically different from the mother cell, which results in genetic variability. That is, modifications to the genetic information resulting in different organisms.
The process of meiosis
As you will see on the following pages, meiosis consists of two consecutive divisions. There is no DNA replication between these divisions, as DNA only replicates during the interphase.
- The first meiotic division separates the pairs of homologous chromosomes. Meiosis I consists of four phases, called prophase I, metaphase I, anaphase I and telophase I.
- The second meiotic division seperates the two sister chromatids in each chromosome. Meiosis II consists of prophase II, metaphase II, anaphase II and telophase II, after which cytokinesis takes place.
60
5
The formation of gametes and meiosis
The germ cells turn into sex cells or gametes, through gametogenesis, which is a process of meiosis. In animals, this process is known as spermatogenesis, when male gametes or spermatozoa are produced, and oogenesis, when female gametes or ova are formed.
1 The first meiotic division takes place. Homologous chromosomes separate into the two daughter cells.
2 The second meiotic division takes place. The chromatids of each chromosome are shared between the two daughter cells.
3 The daughter cells mature into spermatozoa (n).

Understand, think, investigate...
1 The first meiotic division takes place. The homologous chromosomes separate and there is an unequal distribution of the cytoplasm. The larger cell is the oocyte, and the smaller one is the polar body.

2 The second meiotic division takes place. The chromatids of each chromosome are shared between the two daughter cells.
3 The result is the formation of an ovum (n) and three polar bodies (n).
5 What is the difference between oogenesis and spermatogenesis?
6 The What If What would happen if the number of chromosomes that form gametes was not reduced during meiosis? See the resource at anayaeduacion.es to learn how to use this thinking technique.

61
1 2 3 1 2 3 Spermatogenesis Oogenesis
UNIT 2
This is the longest phase of meiosis. During the prophase, the chromatin fibres that were duplicated during the interphase condense and are seen as chromosomes.




Each of the chromosomes recognises its homologous pair and approaches it. The pair closes together like a zip, a phenomenon known as synapsis.
Next, there is an exchange of fragments between non-sister chromatids, a phenomenon known as crossing over. This starts an exchange of hereditary information or genetic recombination between chromosomes.
The pairs of homologous chromosomes remain joined at the crossing over points and align themselves midway down the cell attached to the flilaments of the spindle apparatus.


As they separate, the crossed arms take the fragments of non-sister chromatids with them, as a consequence of the genetic recombination produced in the first meiotic phase. The fibres of the spindle apparatus become shorter and separate the chromosomes of each pair of homologous chromosomes, which move to opposite poles.
The fibres of the spindle apparatus disappear and the chromosomes decondense. The nuclear membrane forms again. Finally, the cytoplasm divides and two daughter cells (n) are formed with half the number of chromosomes.
62 MEIOSIS AND SEXUAL REPRODUCTION X
Prophase I
Anaphase I
Metaphase I
Telophase I and cytokinesis First meiotic division step by step
Prophase II
Metaphase II
Second meiotic division step by step
This division takes place simultaneously in the two cells that are the result of the first division. Without passing through an interphase, the nuclear membrane disappears and the chromosomes become visible again.


The chromosomes align midway down the cell and form a metaphase (equatorial) plate.






The two chromatids in each chromosome separate and migrate, each to one of the cell poles.
Anaphase II
Telophase II and cytokinesis
The chromosomes decondense and chromatin is formed. The nuclear membrane forms.
Understand, think, investigate...
After the telophase, the cytoplasm divides and the organelles are distributed between the daughter cells.
7 Explain the differences between metaphases I and II, anaphases I and II, and the mother cell and daughter cell.
The final result is the formation of four n daughter cells, in other words, cells that have half the chromosomes of the mother cell.
8 Name two types of cells that are generated by meiosis in human beings.
63
UNIT 2
REVIEW & PRACTISE
UNDERSTAND
Organising your ideas
1 Attribute wheel. In your notebook, copy and complete the following chart on the DNA molecule. Visit anayaeducacion.es to learn how to use this graphic organiser.
Formed by two chains of nucleotides twisted into a ?
Each nucleotide is made up of ? , ? and ?
Interpreting pictures
3 Look at the following diagrams and answer the questions:

Both chains are joined by ?
DNA MOLECULES

Both chains are joined by ? Thymine bonds with ? and cytosine bonds with ?

Summarising
There are four types of nitrogenous bases
• ?
• ?
• ?
• ?
Nitrogenous bases do not join ?
The chains are ? It is the base for the ?
2 Use these guidelines to create your own summary of the unit.
• Explain the composition and structure of DNA.
• Name the different types of RNA and list their functions.
• Define transcription and name the molecules involved in the process.
• Define translation and name the molecules that are involved in it.
• Explain what the genetic code is and what it is for.
• Give a short explanation of the different phases of the cell cycle.
• Explain step by step how DNA replication takes place.
• Indicate the main events of each of the phases of mitosis.

• Explain the biological significance of mitosis.
• Establish the difference between cytokinesis in plant and animal cells.
• Define meiosis and explain its biological significance.
• Describe the main events of each of the phases of meiosis.
a) What types of nucleic acid do they show?
b) How are these two biomolecules similar? How are they different?
c) What function(s) do they perform in cells?
4 What process is taking place in the picture below? Which molecules are involved? Explain it step by step.

5 In this diagram you can see a cell in anaphase. Look at the chromosomes and explain whether it is in mitotic anaphase, meiotic anaphase I or meiotic anaphase II. Explain your answer.

64
Base nitrogenada Grupo fostato Azúcar: ribosa o desoxiribosa
A U U G C A A B A A A A G G G T T T T C C C
Applying your knowledge
6 Do the following chains of nucleotides correspond to DNA or RNA molecules? Explain your answers.
a) ACCGGAUCUAGAUCGAUC
b) ACTTAGGCAATCGACGGAT
7 Look at this DNA sequence: TACCCCACTGAGATC
a) Transcribe it into a complementary mRNA molecule.
b) Using the genetic code, translate it into a sequence of amino acids.
8 Explain whether a prokaryotic cell can undergo mitosis? What about meiosis?
9 Complete the following chart about mitosis and meiosis:
10 Write the complementary chain or strand for the following DNA sequence: ATA CCG CAC CCC ATG TCG AT.
11 Explain why prophase I of meiosis is longer than the prophase of mitosis.
12 What type of division will a human hepatic (liver) cell undergo? How many chromosomes will the mother cell have? And the daughter cell?
13 Explain what spermatogenesis is. Where does it take place?
Moving forward
14 Look closely at the tissue cells in the micrograph below. Which phases of mitosis are they in?


Using the scale, calculate the magnification used to take the photo. What type of microscope was used to observe the image?
LEARNING SITUATION
REFLECT AND ASSESS
In this unit you have studied the characteristics of nucleic acids, how they replicate and how cells divide in two different processes: mitosis and meiosis. Assess your achievement by answering these questions and completing the rubric at anayaeduacion.es
I can solve problems related to the characteristics of nucleic acids.
I can analyse the processes of cell division and show them in diagram form.
I can describle the processes of translation, transcription and DNA replication, and explain their function.
TEST YOUR SKILLS
Go to anayaeducacion.es and complete the self-assessment worksheet to test your competencies.
 Remember to choose resources from this unit for your portfolio.
Remember to choose resources from this unit for your portfolio.
CHALLENGES THAT LEAVE AN IMPRINT 65
10 μm
UNIT 2
✔ ✘
? ? ? ? ? ? ? ? ? ? ? MITOSIS MEIOSIS Type of cells it takes place in No. of divisions No. of daughter cells No. of chromosomes in the daughter cells. Is there genetic
recombination?
All rights reserved. No part of this publication may be reproduced, stored in a retrieval system, or transmitted, in any form or by any means, electronic, mechanical, photocopying, recording, or otherwise, without the prior permission of the publishers.
© GRUPO ANAYA, S.A., 2023 - C/ Valentín Beato, 21 - 28037 Madrid.